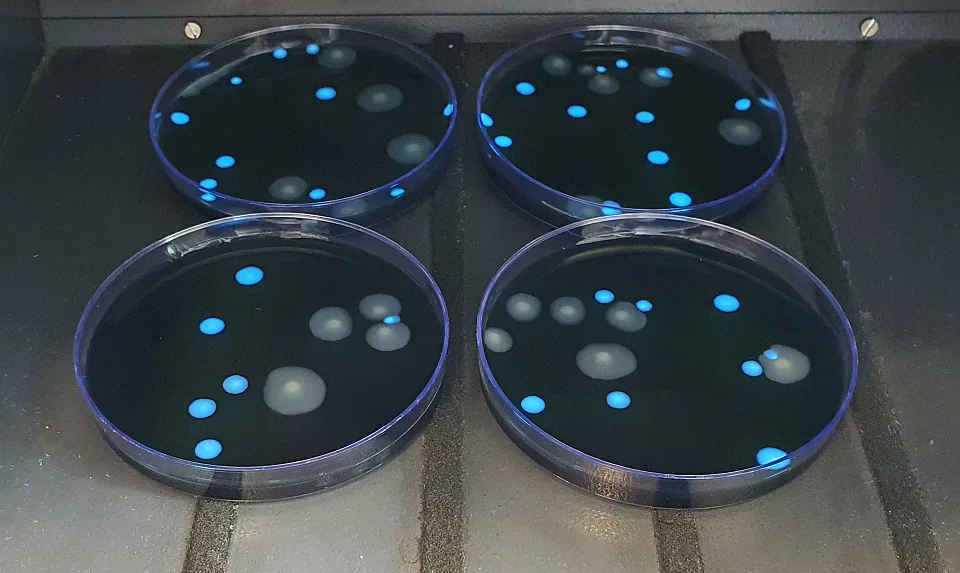
Typisches Wachstum von Legionella pneumophila und Legionella anisa unter UV-Licht

Typisches Wachstum von Legionella pneumophila und Legionella anisa unter UV-Licht
Typisches Wachstum von Legionella pneumophila und Legionella anisa unter UV-Licht
Typisches Wachstum von Legionella pneumophila und Legionella anisa unter UV-Licht
Typisches Wachstum von Legionella pneumophila und Legionella anisa unter UV-Licht